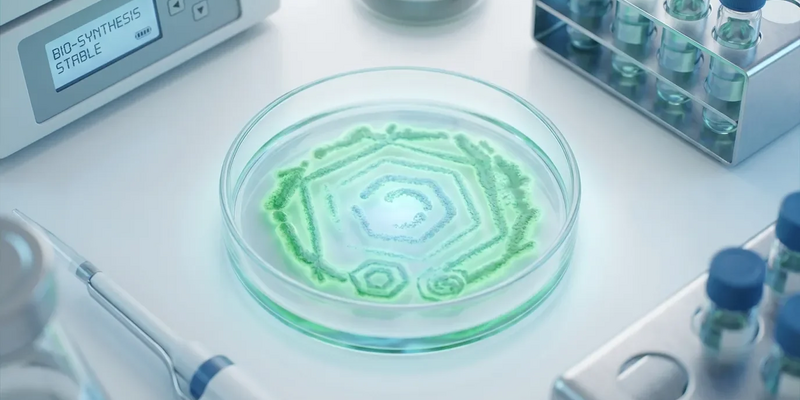
Postbiotika erobern den Gesundheitsmarkt - Foto: über boerse-global.de

Postbiotika erobern den Gesundheitsmarkt
17.01.2026 - 12:09:12Postbiotika lösen Probiotika als Trend der Mikrobiom-Pflege ab. Das zeigen aktuelle Marktanalysen zum Jahresauftakt 2026. Die stabilen, inaktivierten bakteriellen Komponenten machen Darm- und Hautpflege alltagstauglich – von funktionellen Lebensmitteln bis zur Kosmetik.
Experten sehen den Grund für den rasanten Aufstieg in einem entscheidenden Vorteil: Postbiotika müssen nicht lebend im Darm ankommen, um zu wirken. Diese Eigenschaft löst das große Haltbarkeitsproblem ihrer lebenden Vorläufer.
Während lebende Probiotika-Kulturen empfindlich auf Hitze und Sauerstoff reagieren, bleiben Postbiotika auch unter rauen Bedingungen stabil. Diese technologische Überlegenheit eröffnet völlig neue Produktmöglichkeiten.
Sie lesen von der zunehmenden Personalisierung bei Postbiotika – doch welche Blut- oder Vitalwerte sagen, welche Moleküle für Sie wirklich sinnvoll sind? Der kostenlose 25‑seitige Report “Laborwerte‑Selbstcheck” erklärt verständlich, welche Werte wirklich zählen, wann Spezialtests sinnvoll sind und wie Sie Ergebnisse besser einordnen können. Ideal für alle, die Postbiotika oder Nahrungsergänzungen individuell einsetzen wollen; Sofort‑Download per E‑Mail. Jetzt Laborwerte-Report gratis anfordern
Führende Inhaltsstoff-Hersteller wie DSM-Firmenich und Kerry haben ihre Portfolios bereits erweitert. Neue Verfahren ermöglichen die Integration in Produkte, die für lebende Bakterien tabu waren:
* Haltbare Snack-Riegel
* Heißgetränke
* Eine neue Welle funktioneller Lebensmittel jenseits des klassischen Joghurts
Kosmetik setzt auf mikrobielle Helfer
Auch die Hautpflege entdeckt das Mikrobiom neu. Dermatologische Forschungen zeigen: Bestimmte bakterielle Stoffwechselprodukte können die Hautbarriere stärken und Entzündungen lindern – ohne Risiko einer bakteriellen Überwucherung.
Vor allem im „Clean Beauty“-Segment setzen Marken wie Nø Cosmetics bereits auf diese Komplexe. Der Trend geht weg von aggressiven Reinigungsmitteln hin zu einer mikrobiomfreundlichen Pflege. Fermentationsprodukte gelten als sicherer Weg, die Vorteile von Bakterien zu nutzen, ohne lebende Organismen in Cremes konservieren zu müssen.
Ein Milliardenmarkt mit Riesenwachstum
Die wirtschaftliche Dimension des Trends ist immens. Aktuelle Prognosen beziffern das globale Marktvolumen für Postbiotika bereits auf mehrere hundert Millionen US-Dollar – mit zweistelligen jährlichen Wachstumsraten.
Besonders das Segment der Nahrungsergänzungsmittel treibt dieses Wachstum an. Unternehmen wie Sirio Pharma, die früh innovative Darreichungsformen wie Gummis mit Fermentaten einführten, profitieren von der steigenden Akzeptanz. Neue Anwendungsgebiete rücken in den Fokus:
* Klassische Darmgesundheit
* Unterstützung des Immunsystems
* Die sogenannte Darm-Hirn-Achse
Was sind Postbiotika eigentlich?
Der Boom fußt auf einer klaren wissenschaftlichen Definition. Die International Scientific Association for Probiotics and Prebiotics (ISAPP) grenzt die Begriffe scharf voneinander ab:
* Probiotika sind lebende Mikroorganismen.
* Präbiotika sind deren „Futter“.
* Postbiotika sind die funktionellen Endprodukte oder inaktivierten Zellen selbst.
Diese Definition schafft regulatorische Sicherheit. Hersteller können präzise dosieren und Wirkmechanismen besser standardisieren als bei lebenden Kulturen.
Wohin geht die Reise?
Für 2026 und darüber hinaus erwarten Experten eine zunehmende Personalisierung. Die Forschung konzentriert sich darauf, welche spezifischen postbiotischen Moleküle für welche Gesundheitsprofile am effektivsten sind.
Können Postbiotika Stresssymptome über die Darm-Hirn-Achse lindern? Lassen sich Stoffwechselerkrankungen begleiten? Mit fortschreitenden Analysemethoden wird die Identifizierung immer präziser – und ebnet den Weg für maßgeschneiderte Lösungen.
PS: Der Artikel erwähnt die Darm‑Hirn‑Achse – wenn Sie sich um mögliche Folgen für Gedächtnis oder Konzentration sorgen, kann ein schneller Selbstcheck helfen. Der anonyme 7‑Fragen‑Demenz‑Selbsttest liefert in etwa 2 Minuten eine erste Einschätzung und wird per Link in Ihr E‑Mail‑Postfach gesandt. Ideal für Leser ab 50 oder besorgte Angehörige, die diskret Gewissheit suchen. Jetzt den anonymen 7‑Fragen‑Selbsttest machen